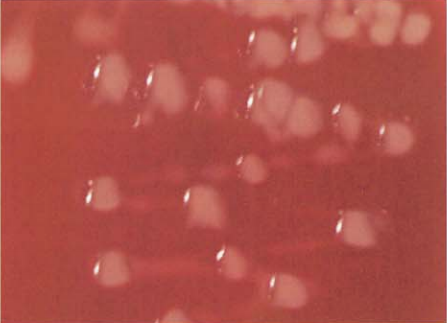
图 1黏液型菌落:马红球菌(96h)
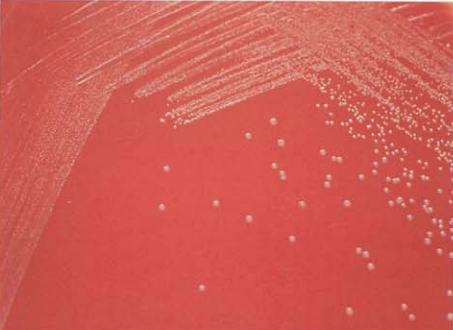
图 6白喉棒杆菌在血琼脂平板上的菌落特征(18~24h)
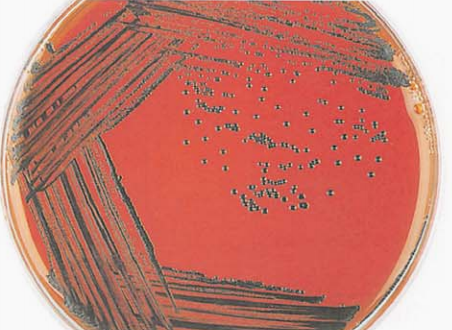
图 7白喉棒杆菌在亚碲酸钾血琼脂平板上的菌落特征(18~24h)

革兰阳性杆菌的鉴定介绍,以及白喉棒杆菌(C. diphtheriae)的生理生化特征
来源:武汉市灰藻生物科技有限公司 浏览量:132 发布时间:2026-02-28 15:17:02
革兰阳性杆菌的鉴定 Identification of Gram positive bacilli
需氧革兰阳性杆菌广泛存在于自然界、水、土壤、动物及人的皮肤和黏膜上,种类繁多,在鉴定上较为复杂,可根据菌落特征、镜下形态、色素和一些主要试验进行初步鉴定。
(一)革兰阳性杆菌的基本特征
在血琼脂平板上生长,在麦康凯、伊红亚甲蓝、中国蓝琼脂平板上不生长的菌落,则提示为革兰阳性杆菌或革兰阳性球菌;
但并非绝对,某些革兰阴性苛养菌,如艾肯菌属、金氏杆菌属、心杆菌属等在血琼脂平板上生长,而在麦康凯平板上不生长。
(二)革兰阳性杆菌的基本鉴定试验要求
触酶试验是鉴定革兰阳性杆菌的重要试验,任何革兰阳性杆菌必须先做触酶试验。
(三)可作为推测性鉴定的重要试验
1. 菌落特征
(1)菌落大小(β溶血、灰白色):较大,疑似芽胞杆菌属;中等,疑似李斯特菌属、放线杆菌属等。
(2)菌落颜色(产色素):
粉红色,马红球菌;
橘红色至红色,红球菌属;
黄色,诺卡菌属、短杆菌属(部分)、微小杆菌属(Exiguobacterium)、橘黄色菌属(Brevibactreium)、金杆菌属(Aureobacium)、纤维单胞菌属(Cellulomonas)、水生棒杆菌(C. aquaticum)、厄氏菌属(Oerskovia);
白色,苏黎世菌属(Turicella);灰白色,白喉棒杆菌。
(3)菌落表面:粗糙、光滑、黏液型、皱纹、放射状等。
图 1 黏液型菌落:马红球菌(96h)
2. 镜下形态
(1)气生菌丝、分生孢子:疑似诺卡菌属、糖单胞菌属、糖多胞菌属、链霉菌属、高温放线菌属。
(2)分枝(分枝大于2个杆菌长度):疑似红球菌属、放线菌属、快速生长分枝杆菌。
(3)Y形分枝杆菌:疑似放线菌属、苏黎世菌属、厄氏菌属(Oerskovia)、马氏棒杆菌(C. matruchotii)。
(4)球杆状:疑似红球菌属、李斯特菌属、厄氏菌属、皮杆菌属(Dermabacter)、短杆菌属。


图 2.革兰阳性杆菌的镜下形态(革兰染色)
A.硬质小麦棒杆菌;B.李斯特菌;C.厄氏菌;D.耳炎苏黎世菌;E.刚果嗜皮菌;F.小单胞菌;G红斑丹毒丝菌;H.马红球菌;I.马杜拉马杜拉放线菌;J.星形诺卡菌;K.化肤隐秘杆菌/溶血隐秘杆菌;L.支气管戈登菌;M.耐酪氨酸冢村菌;N.紫红链霉菌;O.人皮肤杆菌:P.海洋迪茨菌;Q.白喉棒杆菌;R假白喉棒杆菌;S.马氏棒杆菌;T.阴道加特纳菌
(5)抗酸染色:阳性疑似分枝杆菌属,弱阳性疑似戈登菌属、诺卡菌属、红球菌属、冢村菌属。
3. 生化反应
(1)H₂S(TSI)试验阳性的革兰阳性杆菌:猪红斑丹毒丝菌。
(2)CAMP试验阳性的革兰阳性杆菌:产单核细胞李斯特菌、耳炎苏黎世菌、耳棒杆菌、C. glucuronolyticum、纹带棒杆菌、非发酵棒杆菌非发酵亚种、非发酵棒杆菌嗜脂亚种。
(3)触酶试验阳性的革兰阳性杆菌:李斯特菌属、红球菌属、诺卡菌属、芽胞杆菌属、棒杆菌属、苏黎世菌属、皮杆菌属(Dermabacter)、节杆菌属(Arthrobacter)、短小杆菌属(Curtobacterium)、放线菌属。
(4)触酶试验阴性的革兰阳性杆菌:丹毒丝菌属、乳杆菌属、微杆菌属(Microbacterium)、金杆菌属(Aureobactreium)、隐秘杆菌属(Arcanobacterium)。
4. 棒杆菌属之外其他医学相关棒状细菌的鉴别
见表 1。
| 菌名 | 触酶 | 氧化/发酵 | 动力 | 硝酸盐 | 脲酶 | 七叶苷 | 葡萄糖 | 麦芽糖 | 蔗糖 | 甘露醇 | 木糖 | 备注 |
|---|---|---|---|---|---|---|---|---|---|---|---|---|
| 耳炎苏黎世菌 | + | O | – | – | – | – | – | – | – | – | – | CAMP阳性,长的杆菌 |
| 节杆菌属 | + | O | V | V | V | V | V | V | V | – | – | |
| 短杆菌属b | + | O | – | V | – | – | V | V | V | – | – | 奶酪气味 |
| 人皮肤杆菌c | + | F | – | – | – | + | + | + | + | – | V | 小的杆菌 |
| Helcobacillus sp.d | + | F | – | + | – | – | + | + | + | + | – | 水解明胶、淀粉 |
| 龋齿罗氏菌e | V | F | – | + | – | + | + | + | + | – | – | 一些具黏附性,产灰黑色素 |
| 乙酰微小杆菌f | + | F | – | V | – | + | + | + | + | + | – | 产金黄色色素 |
| 混浊(骚动)厄氏菌g | + | F | V | + | – | + | + | + | + | – | + | 不水解黄嘌呤 |
| 纤维单胞菌属 | + | F | V | + | – | + | + | + | + | V | + | |
| 纤维微杆菌属h | + | F | V | V | V | + | + | + | + | – | + | 水解黄嘌呤 |
| 微杆菌属 | V | F/O | V | V | V | V | + | + | V | V | V | |
| 短小杆菌属 | + | O | V | – | – | + | + | V | V | V | + | |
| 水生雷弗森菌 | + | O | + | V | – | V | + | V | V | + | + | |
| Auritidacter ignavus | + | O | + | – | – | – | – | – | – | – | – | |
| 溶血隐秘杆菌 | – | F | – | – | – | – | + | + | V | – | – | 反向CAMP反应i |
| Trueperella bernardiaej | – | F | – | – | – | – | + | + | – | – | – | 糖原阳性 |
| Trueperella pyogenes 化脓菌 | – | F | – | – | – | V | + | V | V | V | + | |
| 阴道加特纳菌k | – | F | – | – | – | – | + | + | V | – | – | 革兰染色不定 |
注:+,阳性反应;–,阴性反应;V,不定;O,氧化;F,发酵。a. CAMP阳性,长的杆菌;b. 奶酪气味;c. 小的杆菌;d. 水解明胶、淀粉;e. 一些具黏附性,产灰黑色素;f. 产金黄色色素;g. 不水解黄嘌呤;h. 水解黄嘌呤;i. 反向CAMP反应;j. 糖原阳性;k. 革兰染色不定
5. 对人类致病的需氧放线菌分类
见图 3。

图 3 对人类致病的需氧放线菌分类
白喉棒杆菌(C. diphtheriae)
棒杆菌属(Corynebacterium)为一群菌体一端或两端膨大呈棒状的革兰阳性杆菌,菌体染色不均匀,呈不规则栅栏状排列。
目前有89个种,与人类有关的棒杆菌有54种,包括白喉棒杆菌(C. diphtheriae)、假白喉棒杆菌(C. pseudodiphtheriticum)、拥挤棒杆菌(C. accolens)、硬质小类杆菌(C. durum)、解葡萄糖苷棒杆菌(C. glucuronolyticum)、C. imitans、杰氏棒杆菌(C. jeikeium)、马氏棒杆菌(C. matruchotii)、假结核棒杆菌(C. pseudotuberculosis)、纹带棒杆菌(C. striatum)、解脲棒杆菌(C. urealyticum)、C. aurimucosum、C. kroppenstedtii、C. resistens、C. tuberculostearicum、C. ulcerans等。
白喉棒杆菌(C. diphtheriae)
(一)白喉棒杆菌形态与染色
革兰阳性,细长微弯,长1.5~5 μm,菌体一端或两端粗大,呈棒状,排列不规则,常呈X、V、L、Y形或栅栏状(图 4)。菌体一端或两端可见浓染颗粒(异染颗粒)。Neisser染色可见菌体内的紫色颗粒(图 5)。

图 4 白喉棒杆菌纯培养的镜下形态(革兰染色)

图 5白喉棒杆菌的异染颗粒(Neisser 染色)
图 5白喉棒杆菌在血琼脂平板上的菌落特征(18~24h)
图 6白喉棒杆菌在亚碲酸钾血琼脂平板上的菌落特征(18~24h)
(二)白喉棒杆菌培养特性
血琼脂平板上35℃培养18~24 h,形成较小、圆形、凸起、光滑、灰白色的菌落,似干酪状,易碎成两半,无或有狭窄溶血环(图 6)。在亚碲酸钾血琼脂平板上形成黑色或灰黑色菌落(图 7)。
(三)白喉棒杆菌生化反应
触酶试验阳性,重型白喉棒杆菌能分解淀粉、糖原和糊精。毒力试验阳性(图 8)。主要生化反应见表 2。

图 8 白喉棒杆菌毒力试验 中间两条接种线在垂直的含白喉抗毒索的滤纸条两侧有白色、弧形的沉淀线,为阳性:上、下两条接种线为阴性和阳性对照
| 试验 | 结果 | 试验 | 结果 |
|---|---|---|---|
| 氧化/发酵 | F | 葡萄糖 | + |
| 硝酸盐 | + | 麦芽糖 | + |
| 脲酶 | – | 吡嗪酰胺酶 | – |
| 蔗糖 | – | 碱性磷酸酶 | – |
| 七叶苷 | – | CAMP试验 | – |
注:+,90%以上菌株阳性;–,90%以上菌株阴性;F,发酵
(四)白喉棒杆菌鉴别要点
1. 本菌特征:革兰阳性棒杆菌,栅栏状排列,有异染颗粒。在亚碲酸钾血琼脂平板上呈黑色或灰黑色的典型菌落。普通培养基上不生长。触酶和硝酸盐还原试验阳性,分解葡萄糖和麦芽糖,毒力试验阳性。
2. 与其他棒杆菌的鉴别:见表 3。
| 菌名 | 氧化/发酵 | 亲脂性 | 硝酸盐 | 脲酶 | 七叶苷 | 吡嗪酰胺酶 | 碱性磷酸酶 | 产酸 | CAMP | ||||
|---|---|---|---|---|---|---|---|---|---|---|---|---|---|
| 葡萄糖 | 麦芽糖 | 蔗糖 | 甘露醇 | 木糖 | |||||||||
| 拥挤棒杆菌 | F | + | + | – | – | V | – | – | – | V | V | – | – |
| 非发酵棒杆菌非发酵亚种 | O | – | – | – | – | + | + | – | – | – | – | – | V |
| 非发酵棒杆菌嗜脂亚种 | O | + | – | – | – | + | + | – | – | – | – | – | V |
| 无枝菌酸棒杆菌 | F | – | V | V | – | + | + | + | V | V | – | – | – |
| 阑尾炎棒杆菌 | F | + | – | + | – | + | + | + | + | – | – | – | ND |
| 畏水棒杆菌 | O | + | – | – | – | + | + | + | – | – | – | – | – |
| 银色棒杆菌 | F | – | – | – | – | + | V | + | – | – | – | – | – |
| 非典型型棒杆菌 | F | – | – | – | – | – | + | + | + | – | – | – | ND |
| 金色黏液棒杆菌 | F | – | – | – | V | + | + | + | + | + | – | – | ND |
| 耳棒杆菌 | O | – | – | – | – | + | + | – | – | – | – | – | + |
| 牛棒杆菌 | F | + | – | – | – | + | + | + | – | – | – | – | – |
| 犬棒杆菌 | F | – | + | + | – | + | + | + | + | – | – | – | – |
| 混淆棒杆菌 | F | – | + | – | – | + | + | (+) | – | – | – | – | – |
| 科伊尔棒杆菌 | F | – | – | – | – | + | + | (+) | – | – | – | – | + |
| CDC group F—1 | F | + | V | + | – | + | – | + | + | – | – | – | – |
| 白喉棒杆菌gravis生物型 | F | – | + | – | – | – | – | + | + | – | – | – | – |
| 白喉棒杆菌中间型 | F | + | + | – | – | – | – | + | + | – | – | – | – |
| 白喉棒杆菌轻型和贝尔凡蒂型 | F | – | + / –a | – | – | – | – | + | + | – | – | – | – |
| 坚硬棒杆菌 | F | – | + | (V) | (V) | + | – | + | + | – | V | – | – |
| 斐氏棒杆菌 | F | – | – | (+) | – | (+) | + | (+) | V | – | – | – | – |
| 弗赖堡棒杆菌 | F | – | + | – | + | – | ND | + | + | + | – | – | – |
| 弗雷尼棒杆菌 | F | – | V | – | – | + | + | + | + | + | – | – | ND |
| 解葡萄糖苷棒杆菌 | F | – | V | V | V | + | V | + | – | – | V | – | + |
| 汉森棒杆菌 | F | – | – | – | – | + | – | + | + | + | – | – | ND |
| 模拟棒杆菌 | F | – | – | – | – | (+) | + | + | + | (+) | – | – | + |
| 杰氏棒杆菌 | O | + | – | – | – | – | – | – | V | – | – | – | – |
| 克氏棒杆菌 | F | + | – | – | + | + | – | + | V | + | – | – | – |
| 喜脂黄色棒杆菌 | (F) | + / – | – | (+) | – | + | + | (+) | – | – | – | – | V |
| 麦氏棒杆菌 | F | + | + | – | – | – | + | + | – | – | V | – | – |
| 马赛棒杆菌 | F | – | – | – | – | (+) | (+) | – | – | – | – | – | ND |
| 马氏棒杆菌 | F | – | + | – | V | + | – | + | + | – | – | – | – |
| 极小棒杆菌 | F | – | – | – | – | + | + | + | V | V | – | – | – |
| 产黏棒杆菌 | O | – | – | – | – | + | + | – | V | – | – | – | – |
| 皮尔巴拉棒杆菌 | F | – | – | – | – | + | + | – | + | – | – | – | ND |
| 丙酸棒杆菌 | O | – | – | V | V | V | V | – | – | – | – | – | – |
| 假白喉棒杆菌 | O | – | + | + | – | + | – | – | – | – | – | – | – |
| 假结核棒杆菌 | F | – | V | + | – | V | + | + | V | – | – | REV | |
| 产丙酮酸棒杆菌 | F | + | – | – | – | + | + | + | + | – | – | – | + |
| 多耐棒杆菌 | F | + | – | – | – | – | + | + | – | – | – | – | – |
| 里格尔棒杆菌 | F | – | – | + | – | V | V | – | (+) | – | – | – | – |
| 模仿棒杆菌 | F | – | + | – | – | V | + | + | – | + | – | – | – |
| 独特棒杆菌 | F | – | – | + | – | + | + | + | – | – | – | – | – |
| 痰棒杆菌 | F | – | – | + | – | + | – | + | – | – | – | – | ND |
| 固态棒杆菌 | F | – | + | + | – | (+) | – | (+) | – | – | – | – | – |
| 纹带棒杆菌 | F | – | + | – | – | + | + | + | V | – | – | – | V |
| 松兹瓦尔棒杆菌 | F | – | + | – | – | V | + | + | + | – | – | – | – |
| 梢氏棒杆菌 | F | – | – | + | – | + | + | + | + | – | – | – | – |
| 提蒙棒杆菌 | F | – | – | (+) | + | + | + | – | – | – | – | – | ND |
| 结核硬脂酸杆菌 | F | + | V | – | – | + | V | + | V | V | – | – | – |
| 图斯卡尼亚棒杆菌 | O | – | – | – | – | + | + | – | – | – | – | – | – |
| 溃疡棒杆菌 | F | – | – | + | – | – | + | + | – | – | – | – | REV |
| 解脲棒杆菌 | O | + | – | – | – | + | V | – | – | – | – | – | – |
| 快速解脲棒杆菌 | F | + | – | + | – | + | + | + | – | – | – | – | (+) ND |
| 结膜干燥棒杆菌 | F | – | – | V | – | – | + | + | + | – | – | – | – |
注:F,发酵;O,氧化;+,90%以上菌株阳性;–,90%以上菌株阴性;+/–,多数阳性,少数阴性;V,不定;(),延迟或弱阳性;ND,无资料。REV, CAMP抑制试验。d. 白喉棒杆菌mitis生物型硝酸盐还原阳性,白喉棒杆菌belfanti生物型硝酸盐还原阴性
3. 与相关棒杆菌的鉴别
见表 4。
| 菌名 | 氧化/发酵 | 触酶 | 动力 | 脲酶 | 硝酸盐 | 七叶苷 | 蔗糖 | 木糖 | 葡萄糖 | 麦芽糖 | 甘露醇 |
|---|---|---|---|---|---|---|---|---|---|---|---|
| 白喉棒杆菌重型 | F | + | ND | – | + | – | – | – | + | + | – |
| 耳炎苏黎世菌 | O | + | – | – | – | – | – | – | – | – | – |
| 节杆菌属 | O | + | V | V | V | V | V | – | V | V | – |
| 短杆菌属 | O | + | – | – | V | – | V | – | V | V | – |
| 人皮杆菌 | F | + | – | – | – | + | + | V | + | + | – |
| 龋齿罗氏菌 | F | V | – | – | + | + | + | – | + | + | – |
| 乙酰微小杆菌 | F | + | – | – | V | + | + | – | + | + | + |
| 骚动厄氏菌 | F | + | V | – | + | + | + | + | + | + | – |
| 纤维单胞菌属 | F | + | V | – | + | + | + | + | + | + | V |
| 纤维单胞菌 | F | + | – | – | + | + | + | + | + | + | – |
| 微杆菌属 | F/O | V | V | V | V | V | V | V | + | + | V |
| 短小杆菌属 | O | + | V | – | – | + | + | + | + | V | V |
| 水生雷弗森菌 | O | + | + | – | V | V | V | + | + | V | V |
| 溶血隐秘杆菌 | F | – | – | – | – | – | V | – | + | + | – |
| 化脓链球菌 | F | – | – | – | – | V | V | + | + | V | V |
| 伯尔德链球菌 | F | – | – | – | – | – | – | – | + | + | – |
注:+,90%以上菌株阳性;–,90%以上菌株阴性;V,11%~89%菌株阳性;ND,无资料;O,为氧化型;F,为发酵型。耳炎苏黎世菌CAMP试验阳性
(五)白喉棒杆菌药敏试验的药物种类选择
药敏试验的药物种类选择依据见表 5。
| 抗菌药物名称 | |
|---|---|
| 必选 | 青霉素、庆大霉素、红霉素、万古霉素 |
| 可选 | 头孢吡肟、头孢噻肟、头孢曲松、美罗培南、达托霉素、环丙沙星、多西环素、四环素、克林霉素、复方磺胺甲噁唑、利福平、利奈唑胺、奎奴普丁-达福普汀 |
注:一般药敏试验结果24 h后可报告,β-内酰胺类药物试验需孵育48 h才能报告结果。上述药敏试验所选药物仅有MIC判读折点,具体参照CLSI M45—A3最新版文件
(六)结果解释与要点提示
(1)白喉棒杆菌是白喉的病原菌,是一种急性呼吸道传染病,主要侵犯口咽、鼻咽等部位,局部形成灰白色假膜,因此得名。该菌一般不进入血液,产生的外毒素可损害心肌和神经系统,病死率高,死亡的病例中50%以上是由于心肌受损发展到充血性心力衰竭所致。此外,可侵犯眼结膜、外耳道、阴道和皮肤伤口等。
(2)临床上遇到疑为白喉的患者时,用棉拭子从炎症部位涂擦采集标本,立即送往实验室。若标本不能及时送往实验室,可直接接种到吕弗血清培养基或亚碲酸盐培养基上。
(3)咽拭子或鼻咽拭子标本的检验程序:制备两张涂片,一张用于革兰染色,另一张用于吕弗亚甲蓝染色。先进行革兰染色,若镜下疑似棒杆菌,再用吕弗亚甲蓝染色后,镜下仔细寻找有无深蓝色的异染颗粒,直接涂片有助于早期的推断性诊断。经革兰染色镜检时观察到大量纺锤形的革兰阴性杆菌和螺旋体而无白喉样的革兰阳性棒杆菌,提示为樊尚病(Vincent's disease)。
(4)在直接涂片上若观察到棒杆菌样的细菌时,最好用吕弗亚甲蓝染色,可以看到细菌呈V、L、Y特征排列,重要的是寻找棒杆菌典型的深蓝色异染颗粒。但是这种白喉杆菌的形态特征并不能与咽喉和鼻咽共栖菌群中的其他棒杆菌区别,直接镜检只能报告“革兰阳性多形性,形态学上类似白喉棒杆菌”。进一步进行培养、生化和毒性试验才能确定诊断。
(5)白喉棒杆菌药物治疗选择见表 6。
| 首选 | 次选 | 其他有效药物 |
|---|---|---|
| 红霉素+抗毒素 | 青霉素+抗毒素 | 据报道利福平有效 克林霉素也有效 |
注:具体参照《热病:桑福德抗微生物治疗指南》(新译第44版)、《国家抗微生物治疗指南》推荐
参考文献
周庭银, 章强强 主编. 临床微生物学诊断与图解(第4版)[M]. 上海: 上海科学技术出版社, 2019.
相关产品
HZB911042:白喉棒杆菌 | Corynebacterium diphtheriae
敬请关注灰藻生物,共筑健康未来!
— 武汉市灰藻生物科技有限公司团队敬上
灰藻生物:我们期待着与客户共同成长,共创生命科学的美好未来!
更新日期:2026-02-28
编制人:木木
审稿人:小藻